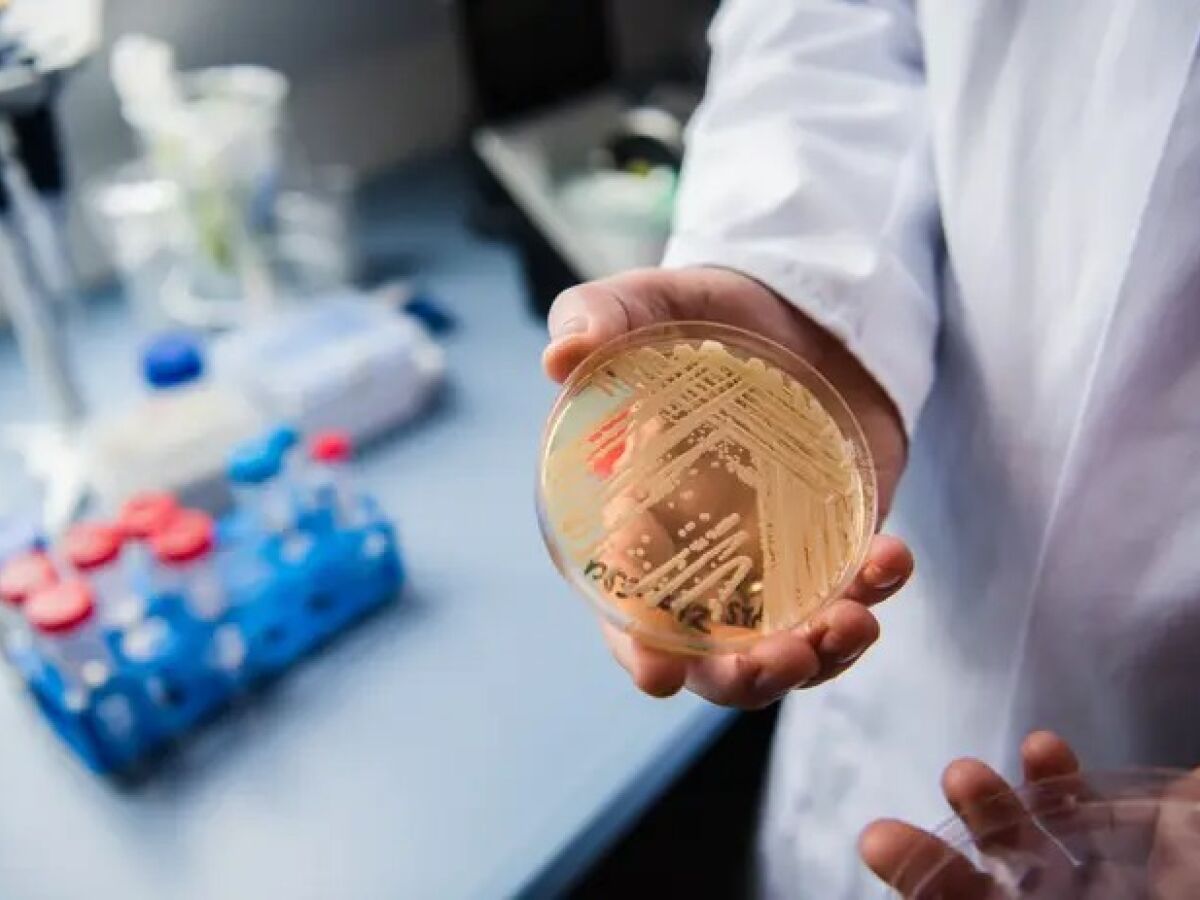

Hospitais de Pernambuco barram novos pacientes após casos de superfungo Candida auris em hospital de Paulista na Grande Recife
Por Edmilson Pereira - em 11 meses atrás 501
Após confirmar o caso de superfungo Candida auris em paciente de 48 anos, o Hospital Miguel Arraes, em Paulista (Grande Recife), precisou suspender os novos atendimentos.
O paciente teve a confirmação de Candida auris no dia 11 de maio.
Dessa forma, o Hospital Miguel Arraes tem recebido apenas pacientes que seguem a classificação de caso de urgência.
Com o fechamento da unidade para receber novos atendimentos, a Secretaria de Saúde de Pernambuco (SES-PE) informa que tem feito o encaminhamento dos pacientes de acordo com o perfil assistencial de cada caso.
“A Central Estadual de Regulação de Leitos segue no monitoramento das unidades da rede estadual de saúde.”
No Hospital do Tricentenário, localizado em Olinda, há outro paciente, de 77 anos, também colonizado com o superfungo Candida auris. Ele teve a confirmação no dia 14 de maio.
Diferentemente do Miguel Arraes, o Hospital do Tricentenário continua a receber novos pacientes.
A SES-PE explica por quê. “No setor onde o paciente está internado, foi estabelecida imediata intensificação das ações de limpeza e desinfecção de ambiente”, diz.
A secretaria ainda acrescenta que o local está isolado para acompanhamento, e a liberação se dará a partir do momento em que seja observada a permanência da negatividade dos resultados laboratoriais nas amostras biológicas do paciente com Candida auris e seus contatos.
Em Pernambuco, os primeiros casos do superfungo Candida auris reconhecidos oficialmente aconteceram em janeiro de 2022: um homem de 67 anos e uma mulher de 70 anos, internados no HR.
O infectologista Flávio de Queiroz Telles Filho, coordenador do Comitê de Micologia da Sociedade Brasileira de Infectologia (SBI), explica que a Candida auris ocorre como infecção hospitalar, que pode causar casos graves de septicemia (condição de resposta exagerada a uma infecção, seja por bactérias, fungos ou vírus) ou apenas colonizar a pele de pacientes. “Mas ela facilmente se mantém dentro de hospitais onde é detectada. É muito difícil de ser erradicada”, frisa.
O maior problema relacionado ao superfungo Candida auris, de acordo com o infectologista Filipe Prohaska, é que esse agente infeccioso é multirresistente a diversos medicamentos antifúngicos. “É um micro-organismo exclusivamente hospitalar”, diz o médico, que se preocupa com o potencial agressivo desse fungo.
Estudos apontam que até 90% dos isolados de Candida auris são resistentes às seguintes medicações: fluconazol, anfotericina B ou equinocandinas.
Outro motivo de preocupação é que a Candida auris pode permanecer viável por longos períodos no ambiente (semanas ou meses) e apresenta resistência a diversos desinfetantes, inclusive os que são à base de quaternário de amônio.
O infectologista Arnaldo Lopes Colombo, professor da Universidade Federal de São Paulo (Unifesp) e referência nacional em contaminação com fungos, informa que o tratamento da Candida auris é feito com antifúngico.
“O único problema é que é um micro-organismo com capacidade de persistir no ambiente hospitalar por muito tempo. Se não forem instituídas medidas de desinfecção adequada, o fungo pode colonizar esses pacientes por tempo prolongado e se tornar resistente a medicações”, alerta o médico.
Além do Recife, a cidade de Salvador já registrou dois surtos provocados pelo superfungo em hospitais: um em 2020; outro em 2021.
A Candida auris é um fungo emergente que representa uma séria ameaça à saúde pública. Ele pode causar infecção de corrente sanguínea e outras infecções invasivas.
Ele pode ser fatal, principalmente em pacientes imunodeprimidos ou com doenças crônicas.
Os pacientes com Candida auris podem não apresentar sinais relacionados à infecção pelo superfungo, mas ter quadro sugestivo de colonização. A diferença entre ambas as condições é que a colonização indica que o paciente está com o fungo, mas não apresenta infecção – e esta ocorre quando há presença de Candida auris na corrente sanguínea.
Fonte: Jornal do Commercio
